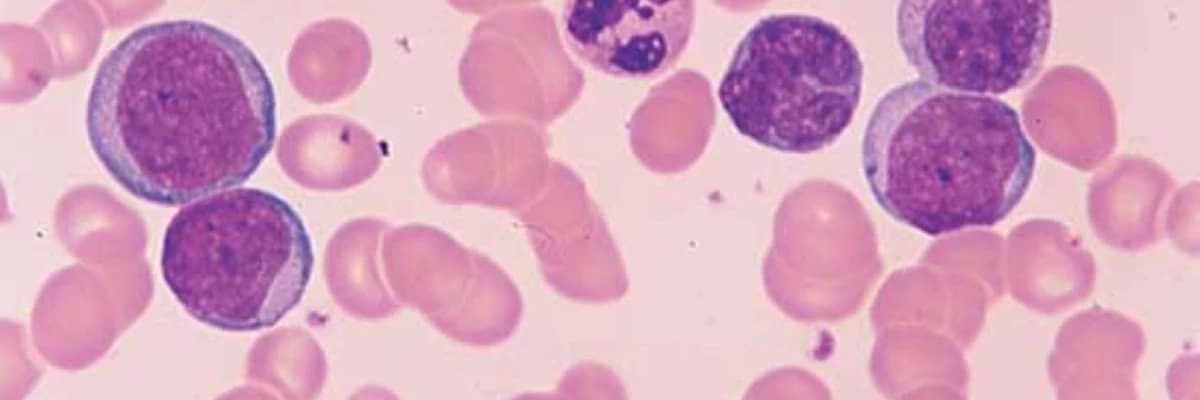
Xroniki Miyeloid Leykemiya (XML)

Xroniki Miyeloid Leykemiya (XML)

Məzmun süni intellekt ilə optimallaşdırılmışdır
Xroniki Miyeloid Leykemiya (KML) Haqqında Əsas Faktlar
Xroniki Miyeloid Leykemiya (KML), qan və sümük iliyini təsir edən, lakin düzgün tibbi yanaşma ilə idarə oluna bilən bir xəstəlikdir. Bu xəstəliyin vaxtında müəyyən edilməsi və müvafiq müalicə planının tətbiq olunması xəstənin həyat keyfiyyəti üçün həlledici rol oynayır. Peşəkar tibbi nəzarət altında KML diaqnozu qoyulmuş bir çox insan uzunmüddətli və sağlam həyat sürə bilməkdədir.
KML-nin Əsas Simptomları və Əlamətləri
Xroniki Miyeloid Leykemiya zamanı müşahidə edilən simptomlar xəstəliyin mərhələsinə görə fərqlilik göstərə bilər. Xəstələrdə ən çox rast gəlinən əlamətlər aşağıdakılardır:
- Çəki itkisi və ümumi zəiflik,
- Anemiya (qanazlığı) nəticəsində yaranan solğunluq,
- Yaraların çox tez qoxuması və ya infeksiyalaşma meyli,
- Qarın nahiyəsində şişkinlik hissi,
- Daimi yorğunluq və yuxusuzluq problemləri.
Diaqnoz Prosesi və Tətbiq Edilən Testlər
Dəqiq diaqnozun qoyulması üçün müasir laboratoriya və kliniki müayinələrdən istifadə olunur. Həkimlər xəstəliyin mövcudluğunu və inkişaf səviyyəsini müəyyən etmək üçün bu metodlara müraciət edirlər:
- Qan testləri: Qan hüceyrələrinin sayını və vəziyyətini yoxlamaq üçün.
- Sümük iliyi biopsiyası: Hüceyrə səviyyəsində daha dərin araşdırma aparmaq üçün.
- Genetik testlər: Xəstəliyə səbəb olan spesifik genetik dəyişiklikləri aşkar etmək üçün.
Müalicə Metodları və Proqnoz
KML-nin müalicəsi kompleks bir prosesdir və tamamilə mütəxəssis həkim tərəfindən fərdi şəkildə müəyyən edilməlidir. Müalicə strategiyasında müxtəlif yanaşmalardan istifadə oluna bilər:
| Müalicə Üsulu | Təsviri |
|---|---|
| Dərman Müalicəsi | Xəstəliyin gedişatını yavaşlatmaq üçün istifadə olunan spesifik preparatlar. |
| Sümük İliyi Transplantasiyası | Sağlam hüceyrələrin bərpası üçün tətbiq edilən cərrahi prosedur. |
| Hüceyrə Kənarlaşdırılması | Şübhəli və zərərli hüceyrələrin bədəndən çıxarılması. |
Xəstəliyin Proqnozu
KML-nin proqnozu, xəstəliyin hansı mərhələdə aşkar edilməsindən və orqanizmin müalicəyə verdiyi cavabdan asılı olaraq dəyişir. Günümüzdə aparılan yaxşı tədqiqatlar və inkişaf etmiş müalicə üsulları sayəsində çox sayda xəstə KML-ni uğurla idarə edir.
Nəticə olaraq, Xroniki Miyeloid Leykemiya şübhəsi yarandıqda, dərhal bir sağlamlıq müəssisəsinə müraciət edilməlidir. Unutmayın ki, həkim müayinəsi və uyğun müalicə planı ilə bu xəstəliyi nəzarət altında saxlamaq mümkündür.